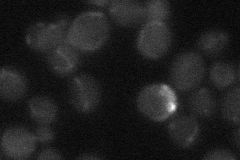
YHR136C
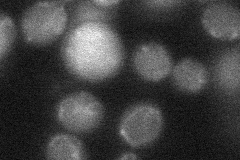
YHR136C

View description
Protein with similarity to cyclin-dependent kinase inhibitors; downregulates low-affinity phosphate transport during phosphate limitation; overproduction suppresses a plc1 null mutation; GFP-fusion protein localizes to the cytoplasm
Localization:
Intensity:
Fold change:
Significance:
-
C’ GFP library in SD

cytosol20.53 -
N' NOP1pr-GFP in SD

below threshold21.1345 -
N' TEF2pr-mCherry in SD

punctate,vacuole9.08196 -
N' NATIVEpr-GFP in SD
below threshold18.4512 -
N' TEF2pr-VC and Cyto-VN in SD
below threshold23.6292 -
C’ GFP library in SD+DTT

cytosol18.490.9No -
C’ GFP library in SD+H2O2

cytosol16.340.79No -
C’ GFP library in Starvation Media

cytosol16.220.78No -
C’ GFP library on the background of Pup2-DaMP

cytosol -
C’ GFP library on the background of CCT mutant

cytosol17.16430.835494No
